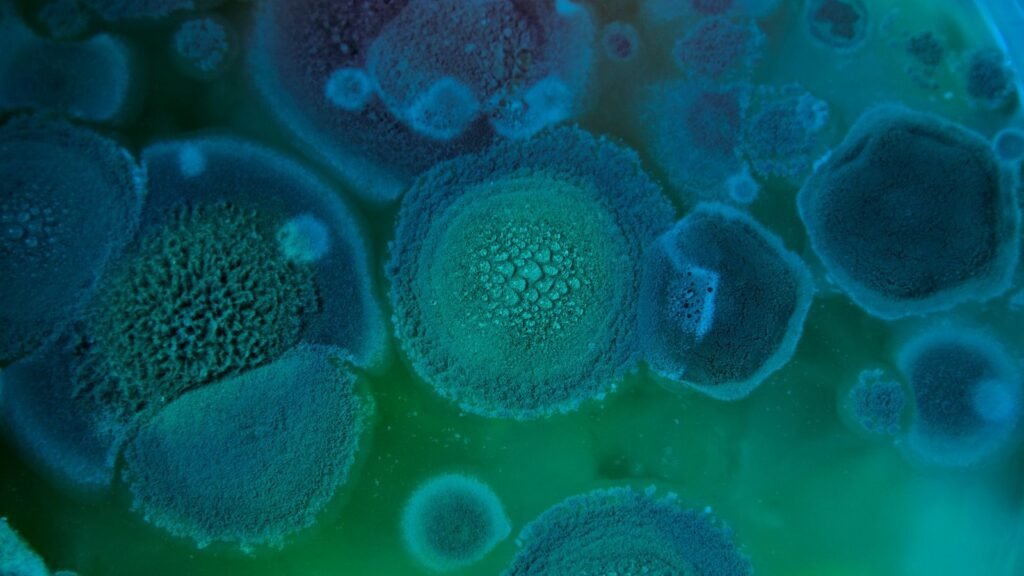

A ideia, popularizada pela série The Last of Us, de que uma pandemia causada pelo fungo Cordyceps poderia transformar humanos em criaturas agressivas parasitadas, possui um certo fundo de realidade. Isso porque, com as mudanças climáticas atuais, diversos fungos patogênicos estão se tornando mais prevalentes e resistentes, aumentando o risco de surtos difíceis de controlar.
Em um estudo recente, ainda não revisado por pares, pesquisadores da Universidade de Manchester alertam que, “com o aumento das temperaturas globais, espera-se que as mudanças climáticas alterem os nichos ecológicos e a disseminação de muitos patógenos fúngicos”, principalmente as espécies do gênero Aspergillus, causadoras de graves infecções em humanos, gado e plantas.
Hospedado no repositório de pré-impressões Research Square, o estudo esclarece que, como os fungos são saprotróficos ambientais, ou seja, se alimentam de matéria orgânica morta, mudanças causadas pelo aumento das temperaturas globais nos lugares onde eles vivem e prosperam podem fazer com que se disseminem para novas áreas onde antes não conseguiam sobreviver.
Um cenário pessimista sobre infestação fúngica
Liderada pelo Dr. Norman van Rhijn, a equipe de Manchester utilizou modelagem e previsões climáticas para mapear como três patógenos fúngicos (Aspergillus flavus, fumigatus e niger) podem se disseminar globalmente em função das mudanças climáticas. Com genomas flexíveis e maleáveis, esses fungos se adaptam facilmente a novas geografias à medida que o ambiente se transforma.
Com base no cenário climático SSP585, do Painel Intergovernamental sobre Mudanças Climáticas (IPCC), o estudo sugere “mudanças para o norte na adequação de todas as três espécies, particularmente sob aquecimento severo”. Na Europa, estima-se que a distribuição de A. flavus aumente 16%, enquanto o A. fumigatus cresça 77,5%, expondo milhões de europeus a infecções pulmonares graves e frequentemente fatais.
As altas taxas de mortalidade por infecções fúngicas se devem à falta de diagnósticos precoces, vacinas e tratamentos eficazes. A dificuldade de desenvolver antifúngicos está relacionada à nossa similaridade biológica com esses organismos: assim como nós, eles são eucariotos. Por isso, um medicamento capaz de matar fungos também pode prejudicar células humanas.
Quais seriam os impactos globais de uma infestação de fungos?

Em comunicado, Van Rhijn afirma: “Já vimos o surgimento do fungo Candida auris devido ao aumento das temperaturas, mas, até agora, tínhamos poucas informações de como outros fungos poderiam responder a essa mudança no ambiente”. Isso acontece porque os fungos ainda permanecem pouco estudados, quando comparados a vírus e parasitas.
Segundo os autores, as mudanças climáticas produzem efeitos paradoxais: enquanto temperaturas elevadas facilitam a disseminação fúngica na Europa, a África pode se tornar excessivamente quente para alguns fungos sobreviverem. Isso é preocupante, pois os fungos são essenciais aos ecossistemas, decompondo matéria orgânica, reintroduzindo nutrientes no solo e contribuindo para o ciclo do carbono, que regula temperaturas globais.
As infecções fúngicas, transmitidas por esporos aéreos, ameaçam especialmente pessoas imunocomprometidas, embora possam também afetar indivíduos saudáveis à medida que esses organismos se adaptam. Hoje eles são mais resistentes devido ao uso agrícola de fungicidas. No entanto, mesmo com riscos crescentes, menos de 10% das espécies fúngicas estimadas foram descritas, pois há poucos recursos para a pesquisa.
Embora não estejamos em Boston, e o Cordyceps real continue afetando apenas formigas e grilos, a crise climática afeta não apenas o clima, mas também a saúde pública. Compartilhe esta matéria, e apoie pesquisas sobre fungos e doenças infecciosas.
Fonte: TecMundo